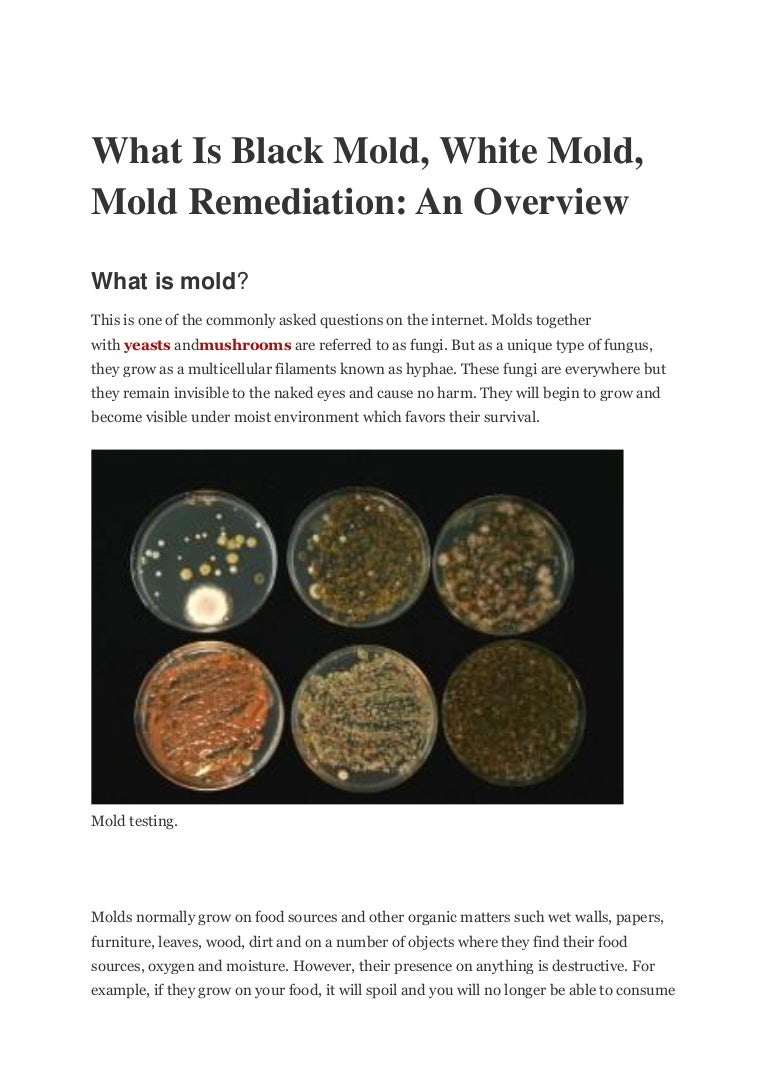

Black mold exposure is no more harmful than exposure to other forms of mold but it may lead to health issues for certain people. Blood andor urine testing is thus the third step in the diagnosis of toxic black mold syndrome.
 Mold Testing For Toxic Molds Black Molds And More Bioidea
Mold Testing For Toxic Molds Black Molds And More Bioidea
Black mold is going to need moisture a food source and oxygen to grow.

Testing for black mold. Testing for and Diagnosing Mold Illness in a Clinical Setting. Several tests are recommended by the doctor to test for mold exposure. To test for mold spores in the air youre breathing youll need to purchase a viable mold test kit which costs 20 to 45.
The Three Main Ways To Test For Black Mold The air testing method is one way to test for black mold. A helpful technique that practitioners of environmental medicine. But not all kits are the same.
Mold kits contain a swab for sampling an affected surface send it into a lab and receive a report indicating what it is. The 5-Minute Mold Test From Healthful Home Products Allows You To Test For Harmful Molds In Your Own Home Or Apartment. A mildewed surface is often difficult to distinguish from a dirty one.
And you have done air quality testing on your home and office and they show high levels of toxic mold spores. Lets shed some light on these tests. Then you should get a toxic mold syndrome diagnosis from your doctor or healthcare worker.
Testing for Black Mold by Kit You can purchase a cheap mold testing kit from most hardware stores. Mold test kits are available in most home improvement or hardware stores and from online retailers. If you find signs of or suspect mold in any of these areas purchase a mold test kit.
No Need To Send Away For Results. Mold test kits work quickly and accurately by detecting black mold early before the problem is too big for you to tackle alone. This kit instructs you to collect a sample from the problem area in your home then you mail your analysis to.
Your doctor takes a blood sample and then sends it to a laboratory to measure the number of certain antibodies which can indicate your immune systems sensitivity to different mold. The samples are collected from the air and then tested in a laboratory. How to test for black mold.
The kits typically include a petri dish a sterile cotton swab and a. To test for mold and mildew and how to tell if your house has mold simply dab a few drops of household bleach on the blackened area. Learn how to find and identify mold and what to do when you have mold.
Theres also black-colored mold that forms in our toilet pretty quickly after cleaning. Information on testing for black mold and detecting black mold in the home or office. If the area remains dark you probably have dirt.
Knowing these basic things will ensure that you sure the proper areas of your home looking for mold instead of wasting your time in areas that it does not grow. When there is a concern about potentially toxic growths a mold detector is a must to determine the exact types and the mold count in a particular environment. Buy Online Or Find The Nearest Store Where You Can Purchase.
When a mold test is ordered Stachybotrys known as black mold or toxic black mold is the strain that most people are trying to rule out or confirm. My husband and I use separate bathroom sinks but both of our sinks have black-colored mold in the sink drains. Get Fast And Accurate Information And Save On Costly Home Inspectors.
These things occur in dark and wet areas. If it lightens after one to two minutes you have mildew. To diagnose mold poisoning or allergies your doctor will go for blood or skin test.
In this test the sample for testing is the patients blood. Some are designed to only determine whether mold is present on surfaces. With the help of a swab test or petri dish you can quickly send samples to a lab and receive test results within a few days.
If you think there may be black mold in your home the Pro Lab Professional Mold Test can help you determine whether you need to call in a professional for remediation. It involves measuring the amount of mold spores in the air in your home. The first thing you need to know before testing for black mold is where black mold is likely to occur at.
 The Best Mold Test Kits To Use For Your Home
The Best Mold Test Kits To Use For Your Home
 Mold Inspection Air Testing In Maryland Mdmoldtestingmdmoldtesting Com
Mold Inspection Air Testing In Maryland Mdmoldtestingmdmoldtesting Com
 Where To Buy Black Mold Test Kits For Home Use Damage Control
Where To Buy Black Mold Test Kits For Home Use Damage Control
/cdn.vox-cdn.com/uploads/chorus_image/image/67644013/iStock_168259571.0.jpg) How To Test For Black Mold This Old House
How To Test For Black Mold This Old House
 Mould Test Kit No Lab Test Available Dampzilla
Mould Test Kit No Lab Test Available Dampzilla
 Black Mold Testing San Jose Benchmark Environmental
Black Mold Testing San Jose Benchmark Environmental
 Black Mold Inspection And Testing Costs Diy Test Kits
Black Mold Inspection And Testing Costs Diy Test Kits
 Is Mold Testing Necessary How To Test Home For Black Mold
Is Mold Testing Necessary How To Test Home For Black Mold
 How To Test For Mold Even If You Can T See It Bob Vila
How To Test For Mold Even If You Can T See It Bob Vila
 Black Mold Testing Toxic Mold Testing Kits For Home And Office Dallas Texas Moldlab Com
Black Mold Testing Toxic Mold Testing Kits For Home And Office Dallas Texas Moldlab Com
 Testing For Black Mold In The Home Or Office
Testing For Black Mold In The Home Or Office
/ScreenShot2020-10-25at10.23.12PM-7de1375fc75842eea5d0115208bf5621.png) The 7 Best At Home Mold Tests Of 2021
The 7 Best At Home Mold Tests Of 2021
Black Mold Test Knowledgeable Black Mold Testing
What Is Black Mold White Mold Mold Remediation An Overview
What Is Black Mold White Mold Mold Remediation An Overview
Mengenai Saya
Cari Blog Ini
Arsip
Arsip
- Juni 202111
- Mei 202115
- April 202123
- Maret 202116
- Februari 202118
- Januari 202117
- Desember 202019
- November 202017
- Oktober 202015
- September 202020
- Agustus 202019
- Juli 202012
- Juni 202016
- Mei 202019
- April 202013
- Maret 202023
- Februari 202013
- Januari 202014
- Desember 201919
- November 201918
- Oktober 201915
- September 201921
- Agustus 201920
- Juli 20199
- Juni 201915
- Mei 201910
- April 20193
Label
- ablation
- abnormal
- acetonide
- acne
- acupressure
- acupuncture
- admitted
- adults
- affect
- affordable
- after
- aftercare
- aids
- alcohol
- alcoholic
- aleve
- alienation
- allergic
- allergies
- allergy
- american
- anemia
- ankle
- announce
- anorexics
- antidepressants
- anxiety
- aortic
- apple
- armpit
- around
- arthritis
- asleep
- average
- away
- babies
- baby
- back
- bacterial
- bagel
- baking
- balls
- banana
- bars
- basil
- bath
- bathe
- bcaa
- beans
- beer
- before
- behind
- belly
- belt
- best
- between
- biometric
- biopsy
- birth
- bite
- bites
- black
- blackhead
- bleach
- blisters
- bloating
- block
- blockers
- blood
- blue
- body
- boiled
- bone
- born
- bowels
- brain
- branch
- breakfast
- breast
- breastfeed
- breastfeeding
- breathe
- broken
- broth
- bruised
- bruises
- buck
- bumps
- bunches
- burger
- burn
- burner
- burning
- busted
- butter
- buttocks
- caffeine
- calories
- cambogia
- cancer
- carb
- carbs
- care
- carnation
- cartilage
- casein
- castration
- cause
- causes
- causing
- cavities
- cell
- cervix
- charcoal
- check
- cheese
- chest
- chicken
- childhood
- children
- chills
- chinese
- chronic
- cider
- cigarette
- clinical
- clogged
- clots
- cloudy
- coconut
- coffee
- cold
- cologuard
- commit
- common
- complex
- concentrate
- concussion
- conjunctivitis
- cons
- considered
- constipation
- contagious
- control
- cook
- coolsculpting
- corona
- cost
- cottage
- cough
- coughing
- count
- covered
- cramps
- crawl
- cream
- creamer
- crepey
- cries
- crying
- cucumber
- cycle
- dairy
- dandruff
- dark
- dayquil
- days
- dead
- dehydration
- depression
- diabetes
- diabetic
- diabeticorum
- diabetics
- diaper
- diet
- difference
- diovan
- disability
- disease
- dizziness
- doctors
- does
- donate
- dosage
- double
- down
- doxycycline
- dried
- drinking
- drinks
- drip
- drug
- dulcolax
- during
- dynamic
- early
- ears
- eating
- eczema
- effects
- effexor
- ejection
- elevation
- eligibility
- elliptical
- emphysema
- endometriosis
- enhancement
- enlarged
- enlargement
- epilator
- epsom
- essential
- estrogen
- exercise
- exercises
- expectancy
- extenze
- extraction
- eyebrows
- eyelids
- eyes
- face
- facts
- fall
- fast
- fathers
- fatigue
- feed
- feel
- fertility
- fever
- fibroglandular
- fibromyalgia
- fills
- fingertip
- first
- flashes
- flea
- floor
- flour
- fluocinolone
- food
- foods
- foot
- forearm
- formula
- fraction
- free
- from
- front
- gain
- garcinia
- garden
- generic
- getting
- giant
- gifts
- giving
- gluten
- good
- grain
- green
- grow
- guys
- hair
- hands
- happens
- have
- head
- headaches
- heal
- healed
- health
- healthy
- Healtline
- hearing
- heart
- heat
- heavy
- helmets
- help
- hemorrhoids
- herbs
- hernia
- herniated
- herpes
- high
- hips
- hives
- holy
- home
- homeopathic
- honey
- hormones
- hurt
- hurts
- hyclate
- hydrochlorothiazide
- hydroxycut
- identical
- implants
- impotent
- induce
- infarction
- infection
- ingrown
- inguinal
- inhaler
- inner
- insertion
- instant
- insurance
- internal
- invasive
- invisalign
- iron
- itself
- jelly
- jerky
- joint
- juice
- juicing
- juvederm
- keflex
- kidney
- kids
- kill
- king
- kiwi
- knee
- krispies
- laser
- last
- late
- left
- legs
- lice
- life
- ligation
- light
- lime
- lips
- lipstick
- liver
- long
- losartan
- lose
- loss
- lotion
- lump
- lung
- lying
- lymph
- lymphoma
- macaroni
- made
- make
- making
- male
- many
- mask
- mayo
- mayonnaise
- mcdonalds
- meal
- meals
- medicare
- medicine
- meningitis
- meniscus
- menopause
- metabolism
- metformin
- migraine
- migraines
- milk
- miracle
- mirena
- miso
- missed
- moisturizer
- mole
- moles
- month
- months
- morning
- mortality
- mosquito
- mouth
- moving
- much
- mucinex
- multiple
- muscle
- mushroom
- myocardial
- myself
- nail
- nails
- narcissist
- nasal
- natural
- naturally
- nausea
- near
- needling
- negative
- nerve
- newborns
- nicotine
- night
- nodal
- nose
- novolin
- novolog
- nsaids
- numb
- nutrition
- nuts
- oatmeal
- oats
- oblique
- ocean
- often
- oils
- olive
- open
- orange
- origin
- ortho
- ovarian
- over
- ovulating
- oximetry
- pack
- pain
- palmetto
- palms
- palpitation
- pancreatic
- parental
- parents
- part
- peanut
- pelvis
- penile
- people
- peppermint
- period
- periods
- peyronies
- phase
- physical
- pillow
- pillows
- pills
- pimples
- pinched
- pineapple
- plan
- plum
- plus
- points
- polish
- popping
- pose
- possible
- post
- powder
- powders
- pregnancy
- pregnant
- pressure
- pretzel
- probiotic
- prognosis
- pros
- protein
- prozac
- psoriatic
- pudding
- pull
- pulse
- purified
- radiating
- rapid
- rate
- rates
- recipe
- recovery
- reduction
- relationship
- relief
- relieve
- remedies
- remedy
- removal
- remove
- remover
- removing
- replacement
- report
- resistant
- restaurants
- retainer
- retainers
- reverse
- review
- reviews
- rice
- right
- rinds
- ringing
- risk
- round
- runners
- safe
- safflower
- salt
- sandwich
- save
- scan
- scars
- schedule
- sclerosis
- screening
- seeds
- septoplasty
- seroquel
- sesame
- shaft
- shakes
- shaving
- shorten
- should
- shoulder
- showing
- side
- signs
- silica
- sinus
- sitting
- skin
- skittles
- skunk
- sleep
- sleeping
- small
- smear
- smell
- smells
- smile
- smiling
- smoke
- smoking
- soaps
- sober
- soda
- soles
- solids
- solution
- soon
- sore
- sores
- soup
- spinach
- splinters
- spot
- spotting
- sprain
- spread
- stage
- stages
- start
- stay
- steel
- stem
- stevia
- stinks
- stomach
- stone
- stones
- stool
- stop
- stopping
- straight
- strengthening
- stretches
- strongest
- stuck
- substitute
- subways
- sugar
- sunburn
- supplement
- supplements
- surgery
- survival
- swelling
- swimming
- swollen
- symptom
- symptoms
- syrup
- system
- tablespoon
- tags
- tail
- take
- tampons
- tattoo
- teeth
- teething
- temporary
- test
- testicular
- testing
- testis
- testosterone
- that
- therapy
- thick
- thighs
- thinners
- throat
- tied
- time
- timeline
- toenail
- toenails
- tongue
- tonsil
- tonsillectomy
- tonsillitis
- tooth
- toothache
- toothpaste
- topamax
- topical
- transplant
- trazodone
- treat
- treatment
- treatments
- trigger
- trimester
- tummy
- tuna
- turbinate
- ultra
- umbilical
- under
- underwear
- undigested
- untreated
- upper
- urine
- vaccine
- valve
- vapor
- vasectomy
- vegan
- veins
- veslcare
- vinegar
- vision
- vitals
- vitamin
- vitamins
- walk
- want
- wash
- water
- ways
- weakness
- weed
- week
- weight
- what
- whats
- when
- whey
- while
- whip
- whiskey
- white
- wild
- will
- wine
- wipe
- wisdom
- with
- within
- without
- women
- womens
- wont
- work
- workout
- wrinkles
- yawn
- years
- yeast
- yellow
- yoga
- your
- yourself
- zone
- zyrtec





